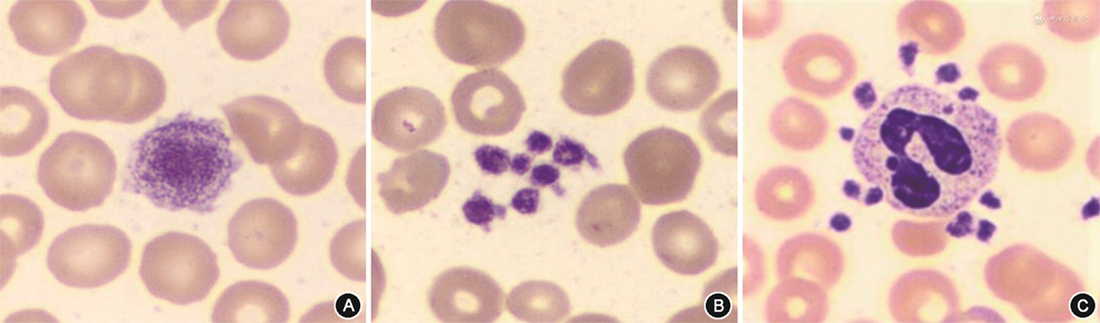

评价全自动数字图像分析(DIA)系统用于外周血细胞形态学分类计数的性能。
选取北京大学第一医院血常规检验外周血涂片379份,疟原虫感染外周血涂片18份,经瑞氏-姬姆萨染色,通过DIA系统完成白细胞(WBC)预分类(DIA直接分类)、再分类(DIA分类后人工审核),以及人工直接显微镜分类。分别计算DIA系统的批内及批间变异系数(CV)进行重复性验证;以人工分类结果为金标准,计算DIA系统检测的灵敏度、特异度、正确率。并对其外周血原始细胞形态学计数、血小板(PLT)形态学计数及疟原虫形态学检查能力进行验证。
除嗜酸粒细胞、嗜碱粒细胞外,DIA系统对正常样本WBC分类的CV均<10%,异常样本WBC分类的CV随所占百分比减低而增大;DIA系统进行WBC预分类的灵敏度、特异度和正确率分别为90.5%、99.2%和98.2%。触发原始细胞报警的血涂片经DIA系统预分类、再分类后,其结果均与人工分类结果具有相关性(r=0.812、0.983,均P<0.01)。DIA系统血小板形态学计数与血细胞分析仪计数结果具有相关性(r=0.946,P<0.01);两种方法计数血小板偏差绝对值<15%;血小板聚集及巨大血小板增多样本偏差绝对值均>15%。经DIA系统采集图像的18份疟原虫阳性外周血涂片,其中17份检出疟原虫滋养体,且图像清晰。
DIA系统进行外周血分类计数的重复性较好,灵敏度、特异度和正确率较高;其预分类、再分类结果与人工分类结果具有相关性。

版权归中华医学会所有。
未经授权,不得转载、摘编本刊文章,不得使用本刊的版式设计。
除非特别声明,本刊刊出的所有文章不代表中华医学会和本刊编委会的观点。
血细胞形态学检验是临床血常规检验中不可或缺的重要环节。血常规检验一般流程为在血细胞分析仪进行全血细胞计数后,对触发复检规则的样本进行人工显微镜细胞形态学复检。目前,临床实验室血常规样本检测量与日俱增,形态学复检样本量随之攀升。由于样本流转时间(TAT)要求严格,加之复检过程需要具有丰富经验的专业人员完成,且人员之间复检结果存在主观性,导致复检样本完成数量及质量受到不同程度地影响。随着全自动数字图像分析(DIA)软件及硬件自动化水平的不断进步,复检效率逐渐提高[1, 2, 3, 4]。但是DIA在血常规检验的应用过程中还存在一些问题,例如对原始细胞的分类计数、血小板(PLT)形态学计数、疟原虫识别等方面的研究不够充分。本研究旨在评价DIA用于外周血白细胞(WBC)分类计数的性能,以及其在外周血原始细胞形态学计数、PLT形态学计数及疟原虫形态学检查这3个血常规检验重要环节的验证。
1. 重复性验证:分别选取2组血细胞分析仪WBC分类正常样本1份,触发复检规则异常样本2例。
2. 白细胞分类性能评价:选取2021年1至3月北京大学第一医院住院患者131份血液样本,包含血细胞分析仪检测结果WBC分类正常样本及触发复检规则异常样本。
3. 其他应用验证:(1)原始细胞相关性验证:选取触发原始细胞报警样本35份;(2)PLT形态学计数与血细胞分析仪计数相关性验证:选取2021年1至5月156份经血细胞分析仪PLT计数无报警血常规样本,包含<20×109/L样本5份,20×109/L~80×109/L样本9份,80×109/L~350×109/L样本131份,>350×109/L样本11份。另外选取触发PLT聚集报警样本29份及触发巨PLT报警样本22份;(3)疟原虫形态学观察评价:选取美国病理学会(CAP)下发疟原虫阳性质控样本13份及留存疟原虫感染患者样本5份(共18例),均为瑞氏-姬姆萨染色薄血涂片。
1. 样本采集:采集受试者静脉血2 ml,注入乙二胺四乙酸二钾(EDTA-K2)抗凝真空管。排除不合格样本。包括脂血、溶血、凝块、采集量不足。
2. 仪器与试剂:DI-60全自动数字图像分析系统(日本Sysmex公司),DxH-800型全自动血细胞分析仪、自动涂片染色仪及原装配套试剂和质控品(美国Beckman-Coulter公司),瑞氏-姬姆萨染液(珠海贝索生物技术有限公司)。
3. 样本检测:在进行样本检测前,先进行高、中、低3个水平质控品检测,结果在控后开始检测。所有样本在采集后2 h内完成检测。将染色后血涂片置于DIA系统,设定DIA自动分类(预分类),计数200个WBC;其结果再由具有丰富经验的形态学检测技术人员进行逐个细胞审核(再分类)。将同一张血涂片在显微镜下分类计数100个WBC并进行形态学观察(人工分类)。为了控制DIA系统细胞定位质量,每日使用正常样本血涂片进行细胞定位校准。
4. 性能验证及应用评价:(1)重复性验证:采用DIA系统对第1组3份血涂片进行10次连续分类计数;对第2组3份血涂片进行每天分类计数1次,连续分类计数10 d。每次检测结果均要进行人工审核(再分类),分别计算批内及批间变异系数(CV)。(2)白细胞预分类性能评价:采用DIA系统进行WBC预分类和再分类,以再分类结果为标准,计算DIA检测的灵敏度、特异度及正确率。(3)DIA与人工分类的相关性:以人工分类结果为“金标准”,计算两种检测方法的相关性,并观察DIA采集的WBC形态特征。(4)原始细胞形态学计数:对35份触发原始细胞报警的样本进行DIA预分类、再分类、人工分类,以人工分类结果为“金标准”,评价预分类、再分类与人工分类的相关性,并观察DIA采集的原始细胞形态特征。(5)血小板形态学计数:对156份外周血样本经血细胞分析仪PLT计数后,制备血涂片,经DIA系统进行PLT形态学计数。评价两种计数方法的相关性,并计算二者绝对值偏差百分比。此外,对血细胞分析仪报警的PLT聚集样本(29份)和巨PLT样本(22份)进行检测,计算绝对值偏差百分比。观察DIA采集的PLT形态特征。(6)疟原虫形态学检查:采用DIA系统对18份疟原虫阳性的薄血涂片进行红细胞及PLT模块图像采集,观察是否存在疟原虫;并与人工镜检结果进行比较。
使用SPSS 22.0统计软件进行数据分析。符合正态分布的计量资料以表示,组间比较采用成组t检验;非正态分布计量资料用95%置信区间表示,组间比较采用非参数Mann-Whitney U检验;计数资料以百分率表示,组间比较采用χ²检验。以人工显微镜计数结果为“金标准”,采用受试者工作特征(ROC)曲线评价DIA系统检测各种血细胞的灵敏度、特异度、正确率。采用Spearman相关性分析进行相关性检验。双侧检验,检验水准α=0.05。
1. DIA系统的重复性评价:正常样本中杆状核中性粒细胞(BN)、分叶核中性粒细胞(SN)、淋巴细胞(LY)、单核细胞(MO)的CV值均<10%;正常样本嗜酸粒细胞(EO)、嗜碱粒细胞(BA)和异常样本全部WBC随百分比减低,CV值增大。DIA系统的批内精密度及批间精密度结果见表1、2。

数字图像分析系统白细胞再分类的批内精密度
数字图像分析系统白细胞再分类的批内精密度
| 项目 | 细胞计数(个,) | CV(%) |
|---|---|---|
| 正常样本 | ||
SN | 64.1±1.3 | 2.0 |
EO | 2.3±0.3 | 13.0 |
LY | 26.4±1.4 | 5.3 |
MO | 7.0±0.3 | 4.3 |
| 异常样本1 | ||
SN | 87.1±1.2 | 1.4 |
EO | 3.8±0.4 | 10.5 |
BA | 0.3±0.3 | 100.0 |
LY | 4.4±0.8 | 18.2 |
MO | 4.5±1.3 | 28.9 |
| 异常样本2 | ||
BN | 15.5±1.4 | 9.0 |
SN | 69.5±1.6 | 2.3 |
EO | 0.2±0.2 | 100.0 |
BA | 1.3±0.3 | 23.0 |
LY | 6.0±1.2 | 20.0 |
MO | 4.2±0.5 | 11.9 |
MN | 3.4±0.3 | 8.8 |
注:SN为分叶核中性粒细胞;EO为嗜酸粒细胞;LY为淋巴细胞;MO为单核细胞;BA为嗜碱粒细胞;BN为杆状核中性粒细胞;MN为中性晚幼核粒细胞;CV为变异系数

数字图像分析系统白细胞再分类的批间精密度
数字图像分析系统白细胞再分类的批间精密度
| 项目 | 细胞计数(个,) | CV(%) |
|---|---|---|
| 正常样本 | ||
BN | 2.4±0.2 | 8.3 |
SN | 64.3±2.0 | 3.1 |
EO | 1.5±0.3 | 20.0 |
BA | 1.1±0.2 | 18.1 |
LY | 23.3±1.9 | 8.2 |
MO | 7.5±0.6 | 8.0 |
| 异常样本1 | ||
BN | 1.5±0.5 | 33.3 |
SN | 36.1±3.3 | 9.1 |
EO | 1.3±0.3 | 23.1 |
BA | 0.7±0.3 | 42.9 |
LY | 55.0±3.7 | 6.7 |
MO | 5.2±0.5 | 9.6 |
RL | 0.2±0.2 | 100.0 |
| 异常样本2 | ||
BN | 8.6±1.7 | 19.8 |
SN | 44.5±2.7 | 6.1 |
EO | 14.0±1.4 | 10.0 |
BA | 0.7±0.3 | 42.9 |
LY | 22.3±0.8 | 3.6 |
MO | 9.9±1.5 | 15.2 |
注:BN为杆状核中性粒细胞;SN为分叶核中性粒细胞;EO为嗜酸粒细胞;BA为嗜碱粒细胞;LY为淋巴细胞;MO为单核细胞;RL为反应性淋巴细胞;CV为变异系数
2. DIA系统的诊断性能评价:采用DIA系统进行WBC预分类和再分类,以人工显微镜计数结果为金标准,DIA系统检测的灵敏度、特异度及正确率见表3。

数字图像分析系统进行白细胞预分类的诊断性能评价
数字图像分析系统进行白细胞预分类的诊断性能评价
| 白细胞种类 | 灵敏度(%) | 特异度(%) | 正确率(%) |
|---|---|---|---|
| 杆状核中性粒细胞 | 52.7 | 99.8 | 94.8 |
| 分叶核中性粒细胞 | 99.7 | 86.9 | 94.7 |
| 淋巴细胞 | 95.9 | 99.4 | 98.8 |
| 单核细胞 | 70.1 | 99.9 | 97.6 |
| 嗜酸粒细胞 | 92.2 | 99.9 | 99.8 |
| 嗜碱粒细胞 | 89.7 | 99.6 | 99.6 |
| 中性中幼粒细胞 | 54.1 | 99.9 | 99.6 |
| 中性晚幼粒细胞 | 66.7 | 99.8 | 99.6 |
| 反应性淋巴细胞 | 14.5 | 99.9 | 99.2 |
3. DIA系统原始细胞形态学计数验证:35份触发原始细胞报警的样本血涂片进行DIA预分类、再分类及人工分类,以人工分类结果为金标准,预分类、再分类均与人工分类结果具有相关性(r=0.812、0.983,均P<0.01)。其中,31份样本再分类与人工分类均见到不同比例原始细胞;1份样本经人工分类浏览全片发现2个原始细胞,DIA系统增加采集细胞数量后进行再分类,发现1个原始细胞;3份样本经DIA再分类及人工分类均未发现原始细胞。DIA采集的原始细胞形态及内部结构清晰,在人工审核时易于辨认(图1)。


4. DIA系统PLT形态学计数验证:DIA系统PLT形态学计数与血细胞分析仪计数结果具有相关性(r=0.946,P<0.05);两种计数方法绝对值偏差百分比为13.14%(95%CI:11.56%~14.73%)。在29份血细胞分析仪PLT聚集报警样本中,有23份样本经DIA系统与人工镜检均见到不同程度PLT聚集,两种方法PLT计数绝对值偏差百分比为30.92%(95%CI:22.09%~42.18%);3份样本人工镜检见到PLT聚集,DIA未见显示,两种方法绝对值偏差百分比分别为33.51%、21.36%、36.78%;另外3份样本经两种方法检测,均未见PLT聚集,绝对值偏差百分比分别为13.16%、12.18%、11.96%。在22份巨PLT报警样本中,19份样本经DIA和人工镜检均见到巨PLT,两种方法绝对值偏差百分比为25.36%(95%CI:15.35%~37.75%);1份样本人工镜检见到巨PLT,DIA未见显示,绝对值偏差百分比为19.76%;另外2份样本经DIA和人工镜检均未见巨PLT,绝对值偏差百分比分别为13.25%、11.61%。DIA系统显示巨PLT、PLT聚集和PLT卫星现象见图2。


5. DIA系统疟原虫形态学检查验证:经DIA系统采集图像的18份疟原虫阳性外周血薄血涂片样本,由经验丰富的检验医师进行图像观察,其中17份检出疟原虫滋养体,且图像清晰;另外1份样本未见疟原虫。18份疟原虫阳性外周血薄血涂片样本直接进行人工镜检,均检出疟原虫滋养体(图3)。


DIA系统与人工分类计数WBC具有较高相关性,对WBC分类的人工辅助识别具有较高灵敏度[3, 4]。本研究对DIA系统的WBC分类计数进行了性能评价,对原始细胞计数和疟原虫检出,特别是PLT形态学计数的性能进行了临床应用验证,并根据研究结果提出了DIA系统在临床应用中的一些规则或措施,在保证约30%复检率的基础上,避免血细胞形态学异常相关疾病及感染性疾病误诊或漏诊。
DIA系统显示的细胞图像完整清晰,分辨率高,可以通过细胞大小、面积、核型等对细胞进行分类。从DIA系统的批内和批间精密度评价结果可见,正常样本的BN、SN、LY、MO的CV值均<10%;正常样本EO、BA和异常样本全部WBC随百分比减低,CV值增大。DIA系统WBC预分类与再分类对各种细胞检出的特异度及正确率都很高,而BN、不成熟粒细胞检出灵敏度较低,反应性淋巴细胞(RL)检出灵敏度最低。因此,在DIA系统分类计数遇到这类WBC时,需通过再分类确认后方可出诊断报告。DIA系统WBC再分类与人工分类结果具有相关性,表明在大多数情况下可以通过再分类,而不必人工分类确认异常细胞,例如不成熟粒细胞和RL。DIA系统在每份样本推染片过程中,均由仪器自动完成,图像采集过程无需人工管理,信息自动储存,有利于统计分析查询。因此,当触发复检规则样本中出现SN、LY、MO、EO、BA百分比增加报警时,只需预分类完成图像采集及人工浏览(无需再分类)加以确认;触发不成熟粒细胞、核左移、RL报警的样本,可经再分类直接报告分类结果,无需人工分类。DIA系统在预分类结果中标有“未被分类细胞”,以涂抹细胞及杂质等最为常见,可以再分类进行确认[1]。虽然细胞成像技术已经高度智能化,但针对大部分DIA检测的血涂片还需进行再分类,将预分类错误的细胞进行修正。在检测特殊病例及血涂片质量欠佳时,人工分类依然是不可或缺的“金标准”。
在形态学检查中,原始细胞检出是难点。本研究对35份原始细胞报警样本进行DIA预分类、再分类及人工分类,预分类与人工分类相关性低于再分类与人工分类的相关性,表明在日常工作中,血常规检验触发原始细胞报警时,DIA必须经再分类确认后,方可发出检验报告。再分类与人工分类具有较高相关性,其中31份样本均查到不同比例原始细胞,1份样本增加采集细胞数量后,两种方法均发现原始细胞,表明两种方法均可通过增加采集细胞数量避免漏检;而DIA可设定自动采集200个及以上WBC进行再分类,工作效率较高;另有3份样本经过两种方法检测,均未检出原始细胞,却均发现一定数量的涂抹细胞,表明可能为血细胞分析仪误报,同时也说明了两种方法检测的一致性。DIA系统还可以将各种类型WBC分类排列在计算机屏幕上,方便观察及比较各种异常细胞形态,即使在原始细胞中有不易观察到的奥氏小体也不会被漏检。原始细胞内发现奥氏小体即可初步判定髓系疾病可能性大,提示临床需进一步行骨髓细胞形态学及其他相关检查,以明确诊断,最好提供外周血细胞检验诊断报告[5],引起临床重视。
血细胞分析仪计数PLT是否准确是临床实验室常常需要决策的问题。血液样本中PLT不同程度聚集或凝集、大或巨PLT[6]、小红细胞或碎片红细胞、白细胞碎片等均可干扰血细胞分析仪PLT计数,引起PLT计数假性减低或假性增高。本研究通过对DIA与血细胞分析仪PLT计数进行比较,发现两种方法的PLT形态学计数有相关性;两种方法计数PLT绝对值偏差百分比为13.14%。而出现PLT聚集与巨PLT样本,两种方法计数绝对值偏差百分比显著升高,分别为30.92%和25.36%。因此,本研究将日常工作中判断两种方法PLT计数结果有差异的绝对值偏差百分比判断上限设定为>15%;凡>15%者,提示血细胞分析仪计数PLT存在干扰因素,需要明确是哪种干扰因素,然后采取适当解决方案,例如更换血液抗凝剂、用光学法或荧光法通道计数PLT、显微镜法或免疫法计数PLT等[7]。另有个别样本经人工镜检可见PLT聚集及巨PLT,而DIA系统未见显示,可能与DIA图像采集部位有关,人工镜检浏览全片,可在血涂片尾部观察到PLT聚集及巨PLT,提示DIA可通过增加图像采集数量的方法来避免漏检。
DIA系统对血液疟原虫感染的形态学自动识别、被感染红细胞的计数还存在一定局限性[4,8]。仅通过DIA系统对已知疟原虫阳性薄血涂片样本采集细胞图像进行人工审核,将审核结果与人工镜检比较,DIA可以在绝大部分样本(17/18)中通过人工审核检出疟原虫感染,表明两种观察方法均可发现疟原虫。1份阳性样本的DIA图像未检出疟原虫,而人工镜检在浏览全片时才检出疟原虫感染,表明临床疑为疟原虫感染的样本,除人工镜检外,DIA亦可通过设定采集多个图像,再进行人工审核,省时省力,避免漏诊。
DIA系统对血液样本推片、染色要求较高,推染片仪器制备的血涂片基本符合图像采集要求,但也会受到染料杂质影响,导致图像采集分类不准确。人工染色血涂片由于受到染色手法、染色时间等多重因素影响,染色质量变化较大,不宜使用DIA进行检测。
所有作者均声明不存在利益冲突